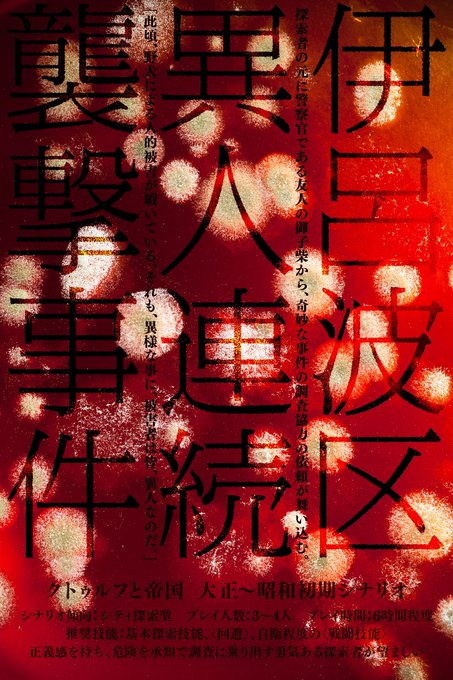

全人類見て〜!!!!
「ヴィクトリアン・アンノウン」
NPCのゴドウィン家3兄弟をうどんさん(@myonaru_U )に描いていただきました✨
家族の肖像写真をイメージして衣装デザインなどもこだわって頂き素敵に仕上げていただきました!
※転載、複写、自作発言等は禁止です
時慈さま、カラーだと目がみどりなんやけどそういうわけなんですなぁ
「Theftring」書いてた時はヴィクアンの構想は無かったけどキャラクターの繋がりは既にあったんだな
地上最強オモロCoCシナリオばかり書いています!!!!!!!!全て最強なので最強のシナリオ同士争いが絶えません!!!!!!!!どうぞ!!!!!!!!!!!!!!!!!!!!!!!!!!!!
https://t.co/OmBZ3XbaLh
探索者の牛嶋みるくちゃん
久しぶりに探索者作ってノリで動かしてたけどめちゃオモロキャラになったな
にこっと!おんなのこメーカーさん
https://t.co/JsAgD8wLN7
🌟声優さん募集中🌟
CoCシナリオ「ヴィクトリアン・アンノウン」オーディオドラマ企画
一緒に作品を作ってくれる♥️ええ声♥️の方を募集中!
下記URLに企画の詳細、応募方法を記載しておりますのでお読みの上ご応募くださいませ!
応募期限 10月13日
https://t.co/n4LcQZwNLE
#声優募集 #CV募集
フォロワッサンが増えたので自己紹介しておこう
クトゥルフ神話TRPGのシナリオを書いている者です🙌🙌🙌
現日、大正、ガスライトシナリオ等…
楽しいけどクトゥルフ神話リスペクトを忘れず!
KPさんが回しやすいシナリオ作りを心がけてます( ◜௰◝و(و "♪
https://t.co/OmBZ3XbaLh